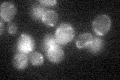
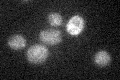

View description
Mitochondrial 3-oxoacyl-[acyl-carrier-protein] reductase, may comprise a type II mitochondrial fatty acid synthase along with Mct1p
Localization:
Intensity:
Fold change:
Significance:
-
C’ GFP library in SD
mitochondria20.09 -
N' NOP1pr-GFP in SD

cytosol46.0763 -
N' TEF2pr-mCherry in SD

cell periphery,vacuole70.8272 -
N' NATIVEpr-GFP in SD

below threshold17.0473 -
N' TEF2pr-VC and Cyto-VN in SD

#N/A0 -
C’ GFP library in SD+DTT

mitochondria32.971.64No -
C’ GFP library in SD+H2O2

mitochondria19.70.98No -
C’ GFP library in Starvation Media
mitochondria21.661.07No -
C’ GFP library on the background of Pup2-DaMP

N/A -
C’ GFP library on the background of CCT mutant

N/A0N/AYes
